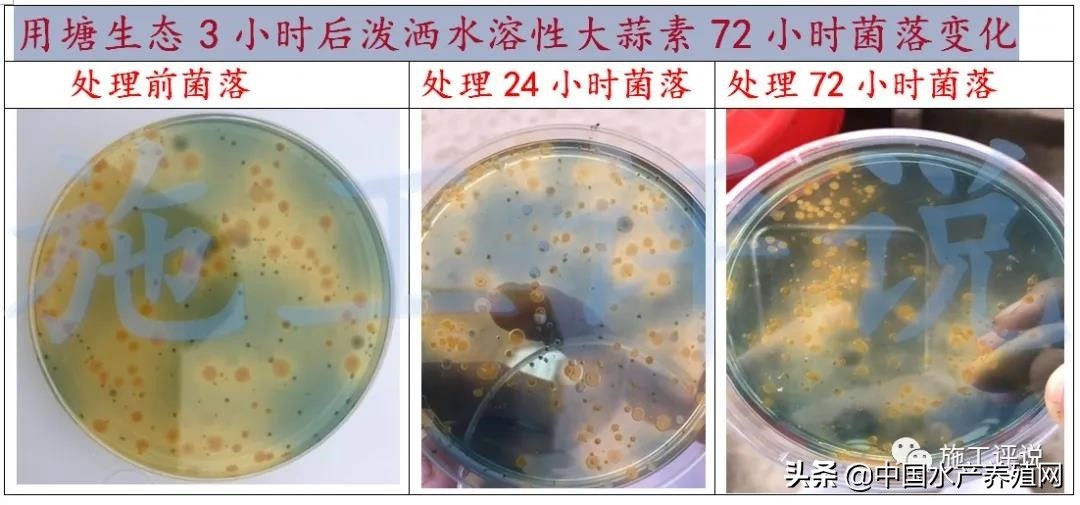
对虾养殖弧菌检测都是黄色小弧菌,对虾弧菌处理的原理是啥

最近听到一个朴实的老养殖户说的一句话:你把弧菌当砖家,弧菌就会把你当傻瓜。这句话细品起来觉得是:话糙理不糙!还是挺在理的。到底弧菌疾病是不是对虾养殖中难以跨越的难关?是否该把弧菌疾病视为水产养殖中的不治之症? 在水产养殖的过程中,如果把养殖管理的重心都围绕着对弧菌的消杀,忽视了消杀对水质的影响、忽视了定期拌喂抗弧菌药物对鱼虾蟹生理的影响。这是否把弧菌作为对虾消化道、养殖水体本来就是应该存在的微生物这一条忘记了?是否本末倒置的把对虾活力低下、水质恶化才是大多数弧菌这些条件性致病菌疾病发生的根本原因这一条忘记了? 弧菌是对虾消化道的正常微生物 对虾体内的肠道寄居着数量庞大、结构复杂的微生物,这些微生物群与对虾相依相制,形成了独特的肠道微生态系统。这些微生物与肠道黏膜共同构成了疾病的防控有力的屏障,保持对虾机体内环境的稳定同时帮助对虾营养消化吸收。 弧菌是对虾肠道内存在的正常菌群,有助于肠道中的碳源代谢利用可能具有潜在的助消化能力,见图1:

在人工养殖中,南美白对虾肠道中的弧菌属是优势菌属,在不同的养殖环境、不同的养殖模式不同,弧菌占肠道总菌数的比例会不同。但是弧菌作为对虾肠道细菌的优势种,在对虾发育到一定阶段,肠道细菌区系趋于相对稳定和成熟,弧菌占细菌总数的比例不易受到外界环境的影响。 但一些弧菌是条件致病菌,养殖过程中当对虾在受到饥饿、养殖水体环境恶化、机械搬运等胁迫时,肠道内的正常菌群可能由于菌群结构失调导致弧菌大量繁殖。而在这种饥饿、养殖水体环境恶化、机械搬运等胁迫条件下,对虾往往会伴有免疫力下降,再加上弧菌数量超过正常值,这就很可能会引起对虾发生弧菌感染的疾病。 弧菌是海水中的常见菌 弧菌是海水中的优势菌群之一,普遍存在于海水、河水、湖水以及人工养殖水域的自然菌群之一,大多数弧菌在水产养殖系统中是一类重要的条件致病菌。 正是因为弧菌是海水中的常见微生物,所以生活于水中的鱼虾蟹等动物在正常状态下,组织内部是无菌的,但在体表和消化道内部却经常定居着包括弧菌在内的各种类型的微生物,这些微生物菌群的组成会随养殖环境变化而不同而有差异。在正常情况下,这些菌群是营腐生生活,不会侵入肌肉而引起动物的病害发生,但当水体环境恶化,整个生态失去平衡时,这种相对的统一就会发生转化,就会引起鱼虾蟹的流行病发生,这种当鱼虾蟹免疫力下降会引起鱼虾蟹的流行病发生的微生物就被称为条件致病菌的微生物。 对虾肠道和养殖水体优势菌的关系 一般对虾肠道和养殖水体具有相同的优势菌,从细菌组成看,虾肠道可培养的细菌种类比养殖水体还多,对虾肠道中存在部分细菌种类而养殖水体没有。这表明对虾肠道菌群与养殖水体有关,也与饲料有关。有观察发现:随着养殖过程的延续,虾池水的盐度逐渐降低,养殖后期虾池水的盐度低到0.5。可能会由于盐度太低的影响,虾池水中弧菌的数量平均只有3.70×104CFU/mL-1,但是在对虾肠道粪样及肠壁上却分别达到2.11×107和2.53×105CFU g-1,这说明弧菌作为对虾肠道细菌的优势种,在对虾发育到一定阶段,肠道细菌区系趋于相对稳定和成熟后,弧菌菌落不易受到外界环境的影响。 许多弧菌是条件致病菌,弧菌感染和治疗的重点是:创造一个符合鱼虾蟹生理需要的养殖水体 弧菌是海水中的优势菌群之一,也是鱼、虾和贝类等等海产动物消化道和体表上的自然菌群之一、也是南美白对虾肠道内存在的正常菌群。 据《中国微生态学杂志》报道:在实验室条件下从病虾的血淋巴液分离出副溶血性弧菌,如果将该菌以肌注途径感染健康成虾,很快就会致病。但把副溶血性弧菌、溶藻性弧菌和鳗弧菌添加入饵料中通过口服的感染试验未获成功,这些都正符合了条件致病菌的特点。弧菌、条件致病菌构成发病作用必须具备三个条件: 一、在养殖水体中条件致病菌要有足够的数量 大多数弧菌在养殖系统中是一类重要的致病菌或条件致病菌, 弧菌数量的多少往往是引发养殖动物发病的一个重要因素, 许多学者将 104cfu·mL-1作为对虾发病的弧菌数量阈值。但是也有调查报道是:虾池弧菌的平均值为1.80x104 cfu·mL-1, 总体偏高,但活力好的对虾依旧生长良好,均未出现发病情况。 二、养殖水体环境条件的适宜 滥用碳源并不一定能够起到以菌抑菌和菌平衡的作用,从碳源利用量来看,弧菌可以利用的碳源多达44种,一旦虾池环境受到滥投料、滥用糖蜜等碳源会导致养殖水体碳污染,弧菌就能优先利用有机碳增殖,若弧菌的增长抑制了其他细菌的生长,整个微生态平衡受到干扰,生态功能下降甚至丧失, 养殖水体的物质循环会受到抑制。目前为了追求碳氮平衡,在养殖过程中滥用碳源的现象并不少见。 当养殖水体中弧菌占据最大优势时,对虾肠道中也会相对存在大量弧菌,对虾就会受到弧菌的攻击,生长受到抑制、免疫力低下,如果再加上外部环境的胁迫就容易弧菌疾病爆发。 可见病害的发生不是特定病原菌引起的,而是环境污染、对虾抵抗力弱、微生态多样性减少的综合结果。 三、对虾等易感动物失去或只有较弱的抵抗力。也就是说,只有在病原菌与宿主的关系失去生态平衡的情况下,才能发病 在水产养殖中,由于饥饿、养殖水体环境恶化、机械搬运等胁迫、纤毛虫等寄生虫感染、脱壳不遂、滥用药物等原因导致对虾免疫力下降是弧菌疾病爆发的主要原因。 所以创造一个符合水产养殖生理需要的水体、提高对虾活力才是预防治疗弧菌疾病的重点。 水质的状况直接和对虾的状态相关 ,在良好水质条件中的对虾活力好,免疫力就好,对疾病的抵抗力较强,不易发生弧菌病。对虾免疫力任何在实际生产中一般可以通过对虾的活力来判断,判断方法可以参考图2:

弧菌致病和水质的关系 一、弧菌感染和水温的关系: 与其他生物一样,弧菌也具有生长的其最高温度、最适温度和最低温度, 温度是影响其生长的重要因子,也是影响弧菌致病的重要条件。福建水产所实验室观察表明:水温在24 ~30 ℃的范围内 ,水体中的哈维氏弧菌的生长及其对日本对虾仔虾的感染死亡率随水温上升而上升 ,在水温≥32 ℃或≤28 ℃时, 哈维氏弧菌的生长速度和仔虾的感染死亡率都随之下降。国外的研究也表明 :水温不仅影响弧菌参与粘附作用的基因表达 ,也影响其毒力基因表达产物的活性。 作为水温除了在室内养殖可以控制外,冬棚和露天池就只能够靠天吃饭了,重点还是保护好水质和提高对虾活力。 二、弧菌感染和盐度的关系: 不同种类的对虾和不同时期的对虾的最适盐度不同 ,如果水体中的盐度高于或低于某种对虾在该生长时期的最适盐度,那么将不同程度地影响对虾的生长,在一定范围内相关越大,影响也越大。盐度 28.7~30.5时,发光弧菌的生长速度和感染死亡率为最高。在养殖生产中,有条件的养殖场可以通过使用淡水把盐度进行相应的调整。 三、弧菌感染和pH的关系: 当养殖水体的pH值长期偏高或者偏低,这时的pH就会成为对虾胁迫因子,导致对虾生理状况低下,弧菌的致病性也明显增强。同时:pH在7.64~8.41的范围内,水体中哈维氏弧菌的生长随pH的降低而递增,但pH值过低时,如降到 5.5以下,哈维氏弧菌的毒力则明显减小。当然:养殖水体的pH不可能那么低,但是:维持养殖水体pH相对稳定这一条是应该做好的的管理工作。 四、弧菌感染和养殖水体肥瘦(COD)的关系: 养殖水体肥瘦(COD)对弧菌的生长有密切的关系,水体中弧菌的生长速度随COD的升高(COD越高水越肥)而上升。 当养殖水体的COD在2.2~6.2mg/L时,也就是养殖水体不至于太肥时,池塘中水体的弧菌的生长较为缓慢,对虾的感染死亡率亦较低。 当养殖水体的COD在8.4~10.2 mg/L时,也就是水太肥了,弧菌的生长速度和虾的感染死亡率迅速上升。 1:养殖水体太肥的应对措施见图4:

2、底泥太肥的应对措施见视频1: 3、根据不同养殖条件,及时纠正水体氨氮亚硝酸盐偏高的现象 1)及时培藻降低养殖水体氨氮、亚硝酸盐见图5:

2)及时改底降低养殖水体氨氮、亚硝酸盐见图6:

3)提高准确使用微生物降低养殖水体氨氮、亚硝酸盐见图7:

4、及时降低水体耗氧量,提高水体溶解氧: 5、准确改底,降低底泥有机质对养殖的影响,避免寄生虫感染导致对虾活力下降诱发弧菌疾病。 准确改底后底泥有机质的状况见视频: 弧菌疾病的治疗 弧菌疾病的治疗和其他生物感染治疗原则基本上一致:消毒+抗菌。 一、弧菌感染时消毒药的选择: 兽药典中消毒药对弧菌都有很好的效果,弧菌对外用消毒药的耐受性并没有水产养殖过程中传说的那么坚强,下图是2009年海军医学研究所舰艇卫生研究室对两种海洋弧菌进行的消毒药敏感试验结果,见图9:

从图9可以看到,弧菌对大多数的化学消毒药都敏感,一些非常普通的、常用的消毒药,对杀灭弧菌都有非常好的效果。 二、弧菌感染时抗菌药的选择: 兽药典中现有的许多抗菌素对弧菌都有一定的效果,弧菌对抗菌素的耐受性并没有水产养殖过程中传说的那么坚强,下图是广东省某大学对两种海洋弧菌进行的药敏试验结果,见图10:

从图10可以看到,弧菌对药典中现有的很多抗菌素都敏感,一些非常普通的、常用的抗菌素,对弧菌都有非常好的效果。治疗弧菌的体内感染并不需要什么神丹妙药。 三、弧菌感染时中草药的选择 药典中现有的许多中药提取物对弧菌都有一定的效果,下图是广东省某大学对两种海洋弧菌进行的药敏试验结果,见图11:

从图11可以看到,弧菌对药典中现有的很多中药提取物都敏感,一些非常普通的、常用的中药提取物,对弧菌都有非常好的效果。从各种中草药对创伤弧菌TO-3的最低抑菌浓度(MIC)和最低杀菌浓度(MBC)结果看,五倍子、诃子对创伤弧菌TO一3的效果显著,黄连、石榴皮、大蒜次之。关键问题是:中药的提取方法要是采用传统的水煮熬,或者直接采用粗粉末中药,效果可能就打几折了。 比如大蒜的提取如下:挑选完好蒜瓣或葱,去皮,加1:1(w/v)溶剂,室温下打浆,浆液浸泡,在4℃条件下离心,取上清液改性成为水溶性再使用。见图12:

在弧菌超标的养殖水体中泼洒水溶性大蒜素的连续3天菌落的结果见图13:
综合弧菌对药典现有的消毒药、抗菌素和中药都是敏感性的,完全不存在合法用药就无法对付弧菌感染的问题。 弧菌反复升高、杀之又生的主要原因 当在生产过程中弧菌超标,但泼洒了消毒药后,感到弧菌杀之不尽时,在正常情况下(也就是用的是真药)先不要考虑:这个药无效或者弧菌有耐药性了,因为外用消毒药一般很少产生耐药性,同时大多数病原性弧菌只有在外界环境条件恶劣,才会大量繁殖。 当生产过程中出现弧菌杀之不尽、消毒当天弧菌减少了可是没几天弧菌又春风吹又生时,这种池塘条件应该先调整一下池塘的理化条件再使用消毒药。 对弧菌处理措施是否有效果的判断,建议最好在用药后连续做几天的弧菌培养,而不是单纯的依靠用药后24小时内的弧菌培养来判断。见图14:

所以不应该把弧菌疾病视为对虾养殖中难以跨越的难关!也不应该把弧菌疾病视为水产养殖中的不治之症!本来就是应该存在于对虾消化道、水体中的微生物--弧菌仅仅是一种条件下致病菌,只有对虾在饥饿、养殖水体环境恶化、机械搬运等胁迫时,对虾免疫力下降时,才可能会引起对虾发生弧菌感染的疾病。 所以,对虾发生弧菌感染疾病预防和治疗重点:创造一个良好的池塘环境和提高对虾活力。 作者:施卫民 来源:施工评说